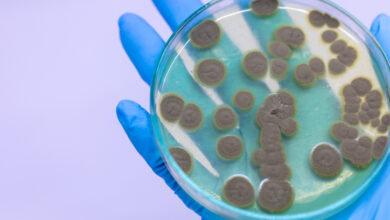
Curiosidades sobre la penicilina que quizás no conozcas

Bienestar General
-

Cerave celebra la naturalidad de la piel durante evento virtual «Acné positivity»
Acné Positivity” se trata de ir más allá de la piel “perfecta” y retocada con herramientas digitales e invita a…
Leer más » -

Be the Match Puerto Rico hace un llamado urgente para unirse a su registro de donantes
Con el objetivo principal de aumentar el registro de donantes y ofrecer esperanza de vida a pacientes con cáncer en…
Leer más » -

¿Los videojuegos pueden propiciar una buena salud?
Los videojuegos suelen tener mala reputación. Pueden evocar imágenes de un niño sentado en el sofá durante horas, renunciando al aire…
Leer más » -

La bursitis del olécranon: ¿qué es?
¿Has oído hablar de la bursitis del olécranon? Aquí te explicamos cómo reconocer y tratar esta patología inflamatoria del codo.…
Leer más » -

Fundación Puertorriqueña del Riñón, 50 años apoyando a sus pacientes
Para celebrar los 50 años de la Fundación Puertorriqueña del Riñón, BeHealth conversó con Ana Maritza Martínez Vizcarrondo, asesora de…
Leer más » -

El bienestar en diferentes áreas es indispensable para una buena calidad de vida
Durante nuestro programa especial “Actúa Por Tu Salud” la Dra. Melba Feliciano destacó la importancia de los programas de bienestar…
Leer más » -

MCS Foundation alcanza cifra histórica de 5.5 millones en ayuda a la comunidad
La cantidad se suma a la aportación de más de 50 mil de horas de voluntariado de los empleados de…
Leer más » -

5 curiosidades sobre la penicilina que quizás no conozcas
Aunque se utiliza en singular, el término penicilina no se refiere a un solo fármaco, sino a un extenso grupo…
Leer más » -

Consejos para evitar o aliviar la migraña
Una vez identificados los factores desencadenantes o agravantes, la persona que sufre de migraña puede desplegar su propia estrategia para…
Leer más » -

Alternativas nutricionales para sustituir la proteína animal en la dieta
Existen muchas alternativas a la proteína animal, pero de origen vegetal, que se pueden incorporar en la dieta, con preparaciones…
Leer más »